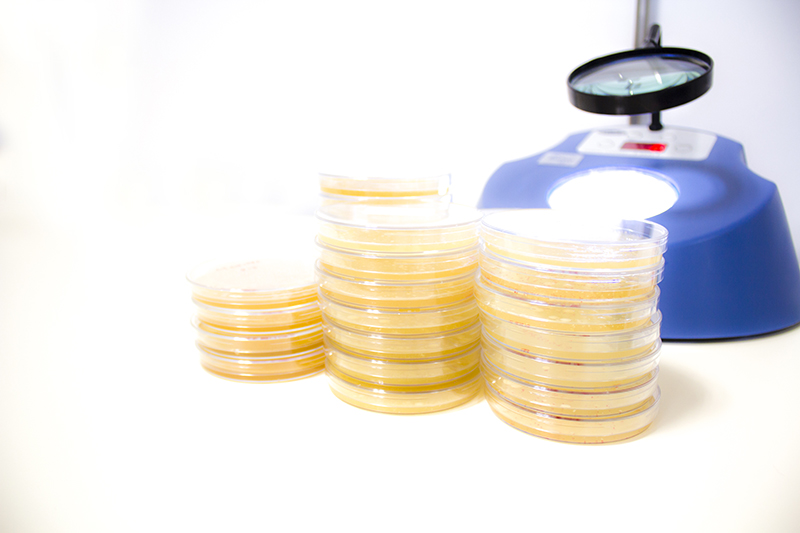

Efficacy/bioactivity tests
Chemical disinfectants and antiseptics
– EN 1276 – Quantitative suspension test for the evaluation of bactericidal activity of disinfectants and antiseptics used in food, industrial, domestic and institutional areas (phase 2, step 1);
– EN 12791 – Hand disinfection for surgical purposes (phase 2, step 2);
– EN 13623 – Quantitative suspension test for the evaluation of bactericidal activity against Legionella of chemical disinfectants in aqueous systems (phase 2, step 1);
– EN 13624 – Quantitative suspension test for the evaluation of fungicidal or yeasticidal activity in medical areas (phase 2, step 1);
– EN 13627 – Quantitative test on non-porous surfaces for the evaluation of bactericidal and/or fungicidal activity of disinfectants and antiseptics used in food, industrial, domestic and institutional areas (phase 2, stage 2);
– EN 13704 – Quantitative suspension test for the evaluation of sporicidal activity of disinfectants and antiseptics used in food, industrial, domestic and institutional areas (phase 2, step 1);
– EN 13727 – Quantitative suspension test for the evaluation of bactericidal activity in medical areas (phase 2, step 1);
– EN 14349 – Quantitative surface test for the evaluation of bactericidal activity of disinfectants and antiseptics used without mechanical action on non-porous surfaces in veterinary areas (phase 2, stage 2);
– EN 14476 – Quantitative suspension test for the evaluation of virucidal activity in medical areas (phase 2, stage 1);
– EN 14561 – Quantitative transfer test for the evaluation of bactericidal activity on utensils used in medical areas (phase 2, step 2);
– EN 14562 – Quantitative transfer test for the evaluation of fungicidal or yeasticidal activity on utensils used in medical areas (phase 2, step 2);
– EN 1499 – Hand hygiene by washing (phase 2, step 2);
– EN 1500 – Hand hygiene by rubbing (phase 2, step 2);
– EN 16438 – Quantitative surface test for the evaluation of fungicidal or yeasticidal activity of disinfectants and antiseptics used without mechanical action on non-porous surfaces in veterinary areas (phase 2, step 2);
EN 1650 – Quantitative suspension test for the evaluation of fungicidal and yeasticidal activity of disinfectants and antiseptics used in food, industrial, domestic and institutional areas (phase 2, stage 1);
– EN 1656 – Chemical disinfectants and antiseptics – Quantitative suspension test for the evaluation of bactericidal activity of disinfectants and antiseptics used in veterinary areas (phase 2, step 1);
– EN 1657 – Quantitative suspension test for the evaluation of fungicidal or yeasticidal activity of disinfectants and antiseptics used in veterinary areas (phase 2, step 1);
– EN 16615 – Quantitative test for the evaluation of bactericidal and yeasticidal activity of disinfectants and antiseptics used with mechanical action on non-porous surfaces using wipes, in medical areas (4-field test) (phase 2, step 2);
– EN 14348 – Quantitative suspension test for the evaluation of the mycobactericidal activity of disinfectants and antiseptics used in medical areas, including utensil disinfectants (phase 2, step 1);
– EN 16777 – Quantitative surface test for the evaluation of virucidal activity of disinfectants and antiseptics used without mechanical action on non-porous surfaces in medical areas (phase 2, step 2);


Textiles
– ASTM E2149-01 – Determination of antimicrobial activity of immobile antimicrobial agents under dynamic contact conditions
ISO 20743 – Determination of antibacterial activity of textile products;
– ISO 20645 – Determination of antibacterial activity. Agar plate diffusion test;
-ISO 13629:2 – Determination of antifungal activity in textile products. Part 2: Plate count method;
– NP EN 14119 – Evaluation of antifungal treatment in textile products;
– ISO 20743 – Determination of antibacterial activity of textile products;
– ISO 16187 – Footwear and footwear components: Methods for the evaluation of antibacterial activity;
– AATCC 100 – Evaluation of antibacterial finish on textile materials;
– ISO 20743 – Textiles – Determination of antibacterial activity of textile products;
– AATCC 147 – Evaluation of textile materials: parallel stripe method;
– ASTM E2149-01 – Determination of antimicrobial activity of immobile antimicrobial agents under dynamic contact conditions;
– ISO 22196 – Determination of antibacterial activity on plastics and other non-porous surfaces;
Plastics
– ISO 22196 – Plastics and non-porous surfaces – antibacterial activity;
– EN 21702 – Determination of antiviral activity on plastics and other non-porous surfaces;


Bioactivity
– Hair products – anti-lice activity;
– Anti-acne;
– Cicatrization;
– Anti-dandruff;
– Deodorising effect;
– Antimicrobial activity;
– Anti-biofilm activity;
– Antiviral testing on surfaces;
Bioequivalence tests
– In vitro drug release studies;
– Skin and vaginal permeation studies;